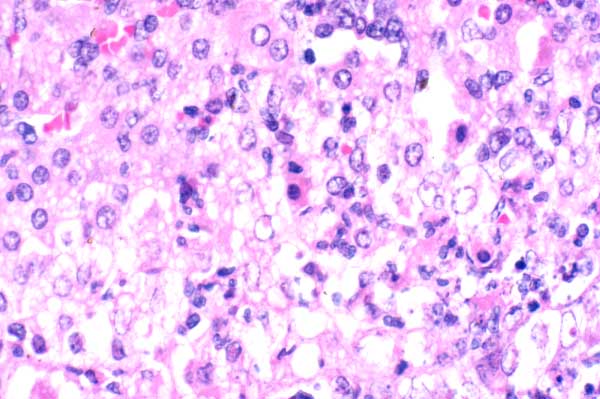

| 40x | Hematoxylin and Eosin | ||||
| Close Window | Macro View | Show Help | Back | |
|
A few adrenal cortical cells are shrunken, with intensely eosinophilic cytoplasm and a pyknotic nucleus (necrosis)(arrows). Remaining cortical cells are swollen with vacuolated cytoplasm (degeneration). There are a few neutrophils.
|
||||

|
||||
| Return | ||||
|
A few adrenal cortical cells are shrunken, with intensely eosinophilic cytoplasm and a pyknotic nucleus (necrosis)(arrows). Remaining cortical cells are swollen with vacuolated cytoplasm (degeneration). There are a few neutrophils.
|
||||